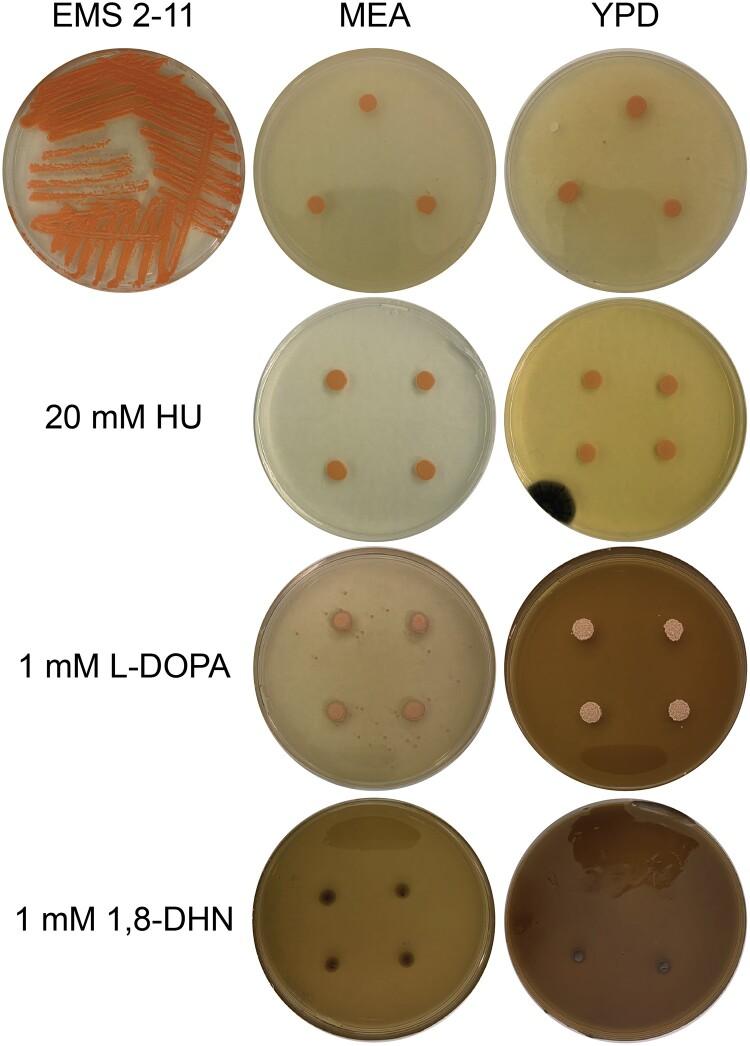
https://cdn.ncbi.nlm.nih.gov/pmc/blobs/f1c2/10411609/cceb4cff3ad8/jkad110f17.jpg

一种新型的多极端耐受真菌——黏性外瓶霉的特性研究,及其黑色素调控和生态位的深入分析。
Characterization of a novel polyextremotolerant fungus, Exophiala viscosa, with insights into its melanin regulation and ecological niche.
机构信息
School of Biological Sciences, University of Nebraska-Lincoln, Lincoln, NE 68588, USA.
Roy J. Carver Department of Biochemistry, Biophysics, and Molecular Biology, Iowa State University, Ames, IA 50011, USA.
出版信息
G3 (Bethesda). 2023 Aug 9;13(8). doi: 10.1093/g3journal/jkad110.
Black yeasts are polyextremotolerant fungi that contain high amounts of melanin in their cell wall and maintain a primar yeast form. These fungi grow in xeric, nutrient depletes environments which implies that they require highly flexible metabolisms and have been suggested to contain the ability to form lichen-like mutualisms with nearby algae and bacteria. However, the exact ecological niche and interactions between these fungi and their surrounding community are not well understood. We have isolated 2 novel black yeasts from the genus Exophiala that were recovered from dryland biological soil crusts. Despite notable differences in colony and cellular morphology, both fungi appear to be members of the same species, which has been named Exophiala viscosa (i.e. E. viscosa JF 03-3 Goopy and E. viscosa JF 03-4F Slimy). A combination of whole genome sequencing, phenotypic experiments, and melanin regulation experiments have been performed on these isolates to fully characterize these fungi and help decipher their fundamental niche within the biological soil crust consortium. Our results reveal that E. viscosa is capable of utilizing a wide variety of carbon and nitrogen sources potentially derived from symbiotic microbes, can withstand many forms of abiotic stresses, and excretes melanin which can potentially provide ultraviolet resistance to the biological soil crust community. Besides the identification of a novel species within the genus Exophiala, our study also provides new insight into the regulation of melanin production in polyextremotolerant fungi.
黑酵母是一种多极端耐受真菌,其细胞壁中含有大量黑色素,并保持原始酵母形态。这些真菌生长在干旱、营养匮乏的环境中,这意味着它们需要高度灵活的新陈代谢,并被认为具有与附近藻类和细菌形成类似地衣的共生关系的能力。然而,这些真菌的确切生态位和与周围群落的相互作用尚不清楚。我们从旱地生物土壤结皮中分离到 2 种新型的外瓶霉属黑酵母。尽管菌落和细胞形态有明显差异,但这两种真菌似乎都是同一个物种的成员,该物种被命名为粘滑外瓶霉(即 E. viscosa JF 03-3 Goopy 和 E. viscosa JF 03-4F Slimy)。对这些分离物进行了全基因组测序、表型实验和黑色素调控实验的组合,以充分表征这些真菌,并帮助破译它们在生物土壤结皮联合体中的基本生态位。我们的研究结果表明,E. viscosa 能够利用多种可能来自共生微生物的碳氮源,能够耐受多种形式的非生物胁迫,并分泌黑色素,这可能为生物土壤结皮群落提供抗紫外线的能力。除了在外瓶霉属中鉴定出一个新物种外,我们的研究还为多极端耐受真菌中黑色素产生的调控提供了新的见解。